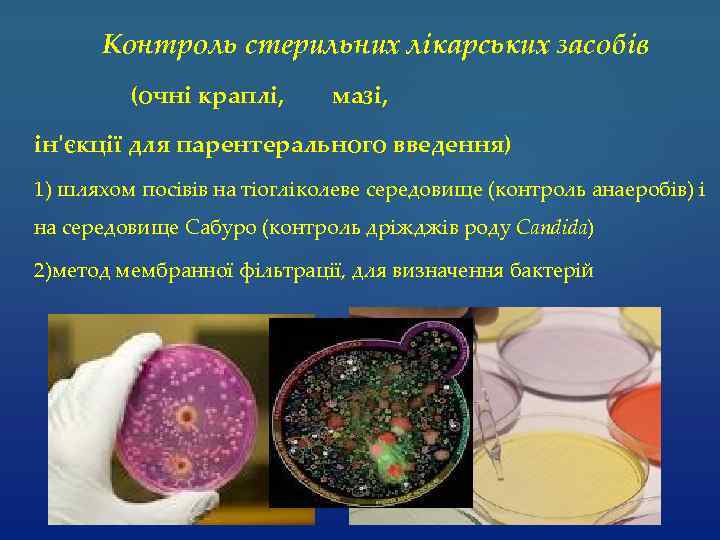
Контроль стерильних лікарських засобів (очні краплі, мазі, ін'єкції для парентерального введення) 1) шляхом посівів

Лекарст раст.ppt
- Количество слайдов: 29
 Рослинна сировина для виготовлення лікарських препаратів
Рослинна сировина для виготовлення лікарських препаратів
 Лікарська сировина - це різні природні матеріали мінерального, тваринного і рослинного походження, які служать джерелами для отримання лікарських засобів
Лікарська сировина - це різні природні матеріали мінерального, тваринного і рослинного походження, які служать джерелами для отримання лікарських засобів
 Джерела контамінації рослинної сировини прижиттєва мікрофлора руки персоналу підлога фітопатогени посуд повітря
Джерела контамінації рослинної сировини прижиттєва мікрофлора руки персоналу підлога фітопатогени посуд повітря
 АНТРОПОГЕННА ЕКСПЛУАТАЦІЯ 1) У лісах і на лугах найменше мікроорганізмів. . 2) Поблизу ферм, на звалищах, пасовищах, полях зрошення найбільше мікроорганізмів.
АНТРОПОГЕННА ЕКСПЛУАТАЦІЯ 1) У лісах і на лугах найменше мікроорганізмів. . 2) Поблизу ферм, на звалищах, пасовищах, полях зрошення найбільше мікроорганізмів.
 НОРМАЛЬНА МІКРОФЛОРА РОСЛИН Фітопатогени Сапрофіти
НОРМАЛЬНА МІКРОФЛОРА РОСЛИН Фітопатогени Сапрофіти
 Сапрофітні мікроорганізми Прикореневої зони Наземної частини
Сапрофітні мікроорганізми Прикореневої зони Наземної частини
 Представники наземної частини Rhizopus nigricans Aspergilus niger Penicillium digitatum Erwima carotovora
Представники наземної частини Rhizopus nigricans Aspergilus niger Penicillium digitatum Erwima carotovora
 МІКРОФЛОРА ПРИКОРЕНЕВОЇ ЗОНИ РОСЛИН 1) спороутворюючі бактерії; 2) актиноміцети; 3) гриби Найчастіше зустрічаються псевдомонади, в тому числі P. fluorescens
МІКРОФЛОРА ПРИКОРЕНЕВОЇ ЗОНИ РОСЛИН 1) спороутворюючі бактерії; 2) актиноміцети; 3) гриби Найчастіше зустрічаються псевдомонади, в тому числі P. fluorescens
 МІКРОФЛОРА РОСЛИН: бактерії віруси гриби
МІКРОФЛОРА РОСЛИН: бактерії віруси гриби
 Псевдомонади Мікобактерії Фітопатогенні бактерії Коринебактерії Агробактерії
Псевдомонади Мікобактерії Фітопатогенні бактерії Коринебактерії Агробактерії
 Коринебактерії викликають: -загальні; -місцеві бактеріози
Коринебактерії викликають: -загальні; -місцеві бактеріози
 Захворювання спричинені агробактеріями 1) своєрідні пухлини (корончатих галлів) 2) утворення онкогенної плазміди
Захворювання спричинені агробактеріями 1) своєрідні пухлини (корончатих галлів) 2) утворення онкогенної плазміди
 Передача збудників бактеріозів Пошкодженні ділянок поверхні здорової рослини насіння грунт При відкритті порів воду комахами, черв'яками повітря
Передача збудників бактеріозів Пошкодженні ділянок поверхні здорової рослини насіння грунт При відкритті порів воду комахами, черв'яками повітря
 ВІРУСНІ ХВОРОБИ РОСЛИН Мозаїчна хвороба Жовтуха
ВІРУСНІ ХВОРОБИ РОСЛИН Мозаїчна хвороба Жовтуха
 Збудники грибкових хвороб рослин 1) Fusarium; 2) Penicillium; 3) Aspergillus
Збудники грибкових хвороб рослин 1) Fusarium; 2) Penicillium; 3) Aspergillus
 Вирощування рослинної сировини здійснюється на спеціальних плантаціях де застосовують заходи боротьби з фітопатогенами
Вирощування рослинної сировини здійснюється на спеціальних плантаціях де застосовують заходи боротьби з фітопатогенами
 Видовий склад і кількість мікрофлори залежать від: - виду рослин; - географічних даних; - кліматичних та інших умов їх росту
Видовий склад і кількість мікрофлори залежать від: - виду рослин; - географічних даних; - кліматичних та інших умов їх росту
 Заходи : - знезараження грунту; -своєчасне видалення поживних залишків; -передпосівна обробка насіння; -обробка витривалих видів; -відлякування та знищення переносників збудників
Заходи : - знезараження грунту; -своєчасне видалення поживних залишків; -передпосівна обробка насіння; -обробка витривалих видів; -відлякування та знищення переносників збудників
 Джерела обнасінення - При заготівлі рослинної сировини; - При зберіганні; - З персоналом
Джерела обнасінення - При заготівлі рослинної сировини; - При зберіганні; - З персоналом
 ЕКСТРАКЦІЙНІ ПРЕПАРАТИ Настоянки Екстракти
ЕКСТРАКЦІЙНІ ПРЕПАРАТИ Настоянки Екстракти
 Настоянками називають рідкі спиртові, спиртово-водні, спиртово-ефірні витяжки фармакологічно активних речовин з лікарської рослинної сировини, що отримують нагріванням і видаленням екстрагента Густину Вміст спирту Контролюють Сухий залишок Важкі метали
Настоянками називають рідкі спиртові, спиртово-водні, спиртово-ефірні витяжки фармакологічно активних речовин з лікарської рослинної сировини, що отримують нагріванням і видаленням екстрагента Густину Вміст спирту Контролюють Сухий залишок Важкі метали
 Екстрати - концентровані витяжки із лікарської рослинної сировини Контролюють Важкі метали Сухий залишок Вологість
Екстрати - концентровані витяжки із лікарської рослинної сировини Контролюють Важкі метали Сухий залишок Вологість
 Лікарські засоби поділяються на Абсолютно стерильні Які не потребують стерилізації
Лікарські засоби поділяються на Абсолютно стерильні Які не потребують стерилізації
Контроль стерильних лікарських засобів (очні краплі, мазі, ін'єкції для парентерального введення) 1) шляхом посівів на тіогліколеве середовище (контроль анаеробів) і на середовище Сабуро (контроль дріжджів роду Candida) 2)метод мембранної фільтрації, для визначення бактерій
Контроль стерильних лікарських засобів (очні краплі, мазі, ін'єкції для парентерального введення) 1) шляхом посівів на тіогліколеве середовище (контроль анаеробів) і на середовище Сабуро (контроль дріжджів роду Candida) 2)метод мембранної фільтрації, для визначення бактерій
 Загальну кількість бактерій Гриби У нестерильних лікарських засобах контролюють Ентероб актерії Синогнійні палички Золотисти й стафілокок
Загальну кількість бактерій Гриби У нестерильних лікарських засобах контролюють Ентероб актерії Синогнійні палички Золотисти й стафілокок
 Таблетована форма - Відсутність патогенних мікроорганізмів; - Загальна обнасіненість менше 10 000 клітин на таблетку
Таблетована форма - Відсутність патогенних мікроорганізмів; - Загальна обнасіненість менше 10 000 клітин на таблетку
 Лікарські засоби місцевого застосування (мазі, гелі та ін. ) Не більше 100 клітин в 1 г або мл
Лікарські засоби місцевого застосування (мазі, гелі та ін. ) Не більше 100 клітин в 1 г або мл
 Лікарські засоби внутрішнього застосування Не більше 1000 клітин в 1 г або мл Дріжджів і грибів - не більше 100
Лікарські засоби внутрішнього застосування Не більше 1000 клітин в 1 г або мл Дріжджів і грибів - не більше 100
 Дякую за увагу
Дякую за увагу


